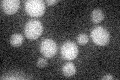
YDR432W
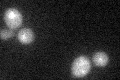
YDR432W

View description
RNA-binding protein that promotes elongation, regulates termination, and carries poly(A) mRNA from nucleus to cytoplasm; required for pre-mRNA splicing; dissociation from mRNAs promoted by Mtr10p; phosphorylated by Sky1p in the cytoplasm
Localization:
Intensity:
Fold change:
Significance:
-
C’ GFP library in SD
cytosol18.79 -
N' NOP1pr-GFP in SD

nucleus330.598 -
N' TEF2pr-mCherry in SD

nucleus172.328 -
N' NATIVEpr-GFP in SD

nucleus350.118 -
N' TEF2pr-VC and Cyto-VN in SD

#N/A0 -
C’ GFP library in SD+DTT
cytosol15.440.82No -
C’ GFP library in SD+H2O2

cytosol16.220.86No -
C’ GFP library in Starvation Media

cytosol14.420.76No -
C’ GFP library on the background of Pup2-DaMP

N/A -
C’ GFP library on the background of CCT mutant

N/A0N/AYes
